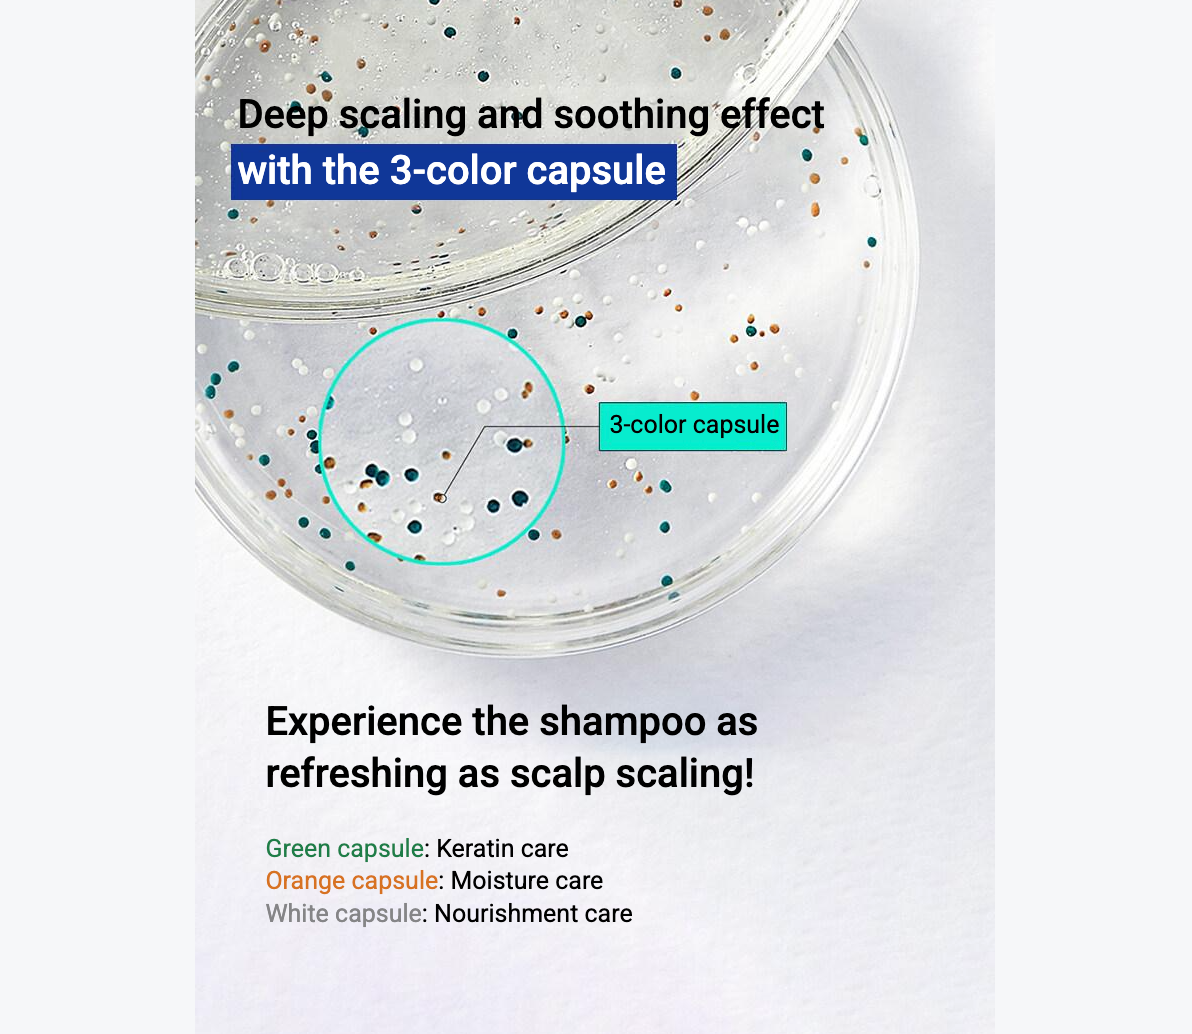

Heraldsilver Inc.
【LABO-H】 Hair Loss Care Shampoo (Scalp cooling) / 400ml
【LABO-H】 Hair Loss Care Shampoo (Scalp cooling) / 400ml
Couldn't load pickup availability
LABO-H Hair Loss Relief Scalp Cooling Shampoo
● Product Details
-
Brand: LABO-H
-
Condition: New, with box
-
Content Volume or Weight: 400ml
-
Expiration Date: We will send you the most recent products.
-
Made in Korea / Ship from Korea: Authentically made in and shipped directly from South Korea.
● Product Description
A functional anti-hair loss shampoo that delivers an instant and lasting scalp cooling effect. Formulated with probiotics found in green tea and herbal ingredients, it relieves scalp irritation, reduces sebum, and improves hydration. It provides a refreshing, scalp-scaling effect for a clean and healthy scalp environment.
● Benefits
-
Instant & Long-lasting Cooling: Clinically proven to reduce scalp temperature immediately with a 24-hour lasting sensation.
-
Hair Loss Relief: Certified by the Ministry of Food and Drug Safety (Korea) as a functional product for hair loss relief.
-
Itchiness & Sebum Control: Soothes scalp itchiness immediately and removes excess sebum while boosting hydration.
-
Refreshing Experience: Delivers a deep-cleansing, scaling effect that revitalizes the scalp.
● How to Use
Use once a day. Wet your hair and scalp with lukewarm water, then apply a generous amount and distribute evenly. Leave on for 2–3 minutes to allow for maximum absorption before rinsing thoroughly with warm water.
● Key Ingredients
-
Probiotics (Lactobacillus Ferment Lysate): Sourced from green tea to strengthen and balance the scalp environment.
-
Menthol & Peppermint Oil: Delivers an immediate and refreshing cooling sensation to heated scalps.
-
Caffeine & Ginseng Extract: Works to strengthen hair roots and support overall scalp health.
-
Green Tea Leaf Water & Extracts: Provides essential soothing and hydration to irritated areas.
● Key Highlights
-
High Satisfaction: 100% user satisfaction in cooling performance and relief from oiliness and itchiness.
-
Natural Nutrition: Contains soybean extract and a blend of natural oils like Rosemary and Eucalyptus to nourish the scalp.
-
Proven Performance: Clinically tested for instant temperature reduction after just one use.
#LABOH #HairLossRelief #ScalpCooling #AntiHairLoss #Kbeauty #ScalpCare #GreenTeaProbiotics #CoolingShampoo #ScalpScaling #HairCare #Authentic
Share